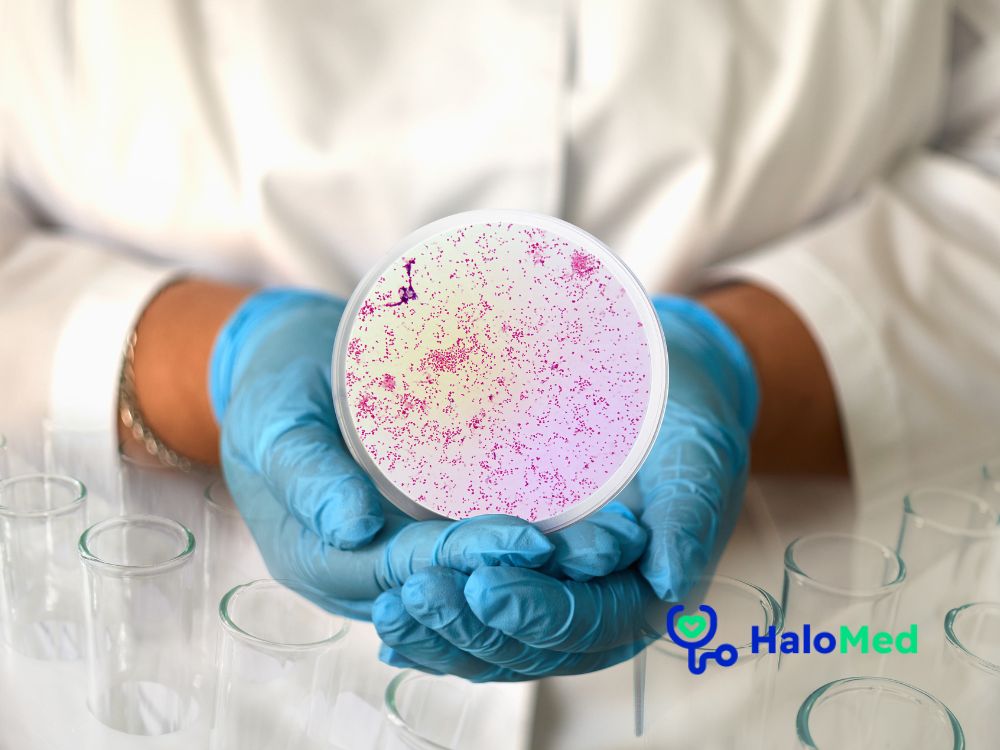

Beata Obrocka
O mnie:
Jestem absolwentką Akademii Medycznej w Łodzi. Po studiach byłam promowana na stopien podporucznika i rozpoczęłam pracę w Wojskowym Instytucie Medycznym w Warszawie. ( 5 lat na SOR, 15 - lat w Klinice Onkologii ). W tym czasie ( 20 - lat ) zdobyłam następujące specjalizacje: z chorób wewnętrznych, chemioterapii nowotworów i onkologii klinicznej. Po przejściu w stan spoczynku w stopniu majora rozpoczęłam pracę w Oddziale Onkologii Luxmed Onkologia w Warszawie. Przez kilka lat pełniłam funkcję Ordynatora tego Oddziału. Obecnie pracuję w charaktrzrze internisty w Kot Center w Otwocku, w Halomedzie i uczestniczę w Konsyliach Onkologicznych w Szpitalu Międzyleskim.
Informacje dodatkowe
 Specjalista:
Specjalista: Data i godzina:
Data i godzina: Usługa:
Usługa: Specjalizacje:
Specjalizacje:Pozostali lekarze